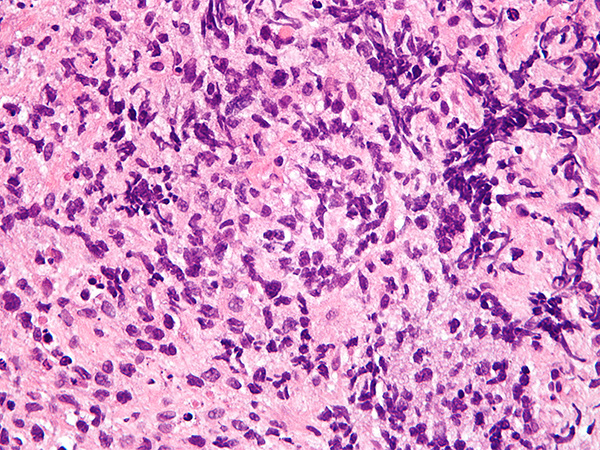

A New Immunotherapeutic for Non-Hodgkin Lymphoma
The FDA has expanded the use of pembrolizumab to treat certain patients with non-Hodgkin lymphoma.
The U.S. Food and Drug Administration (FDA) recently
approved pembrolizumab (Keytruda) as a treatment option for certain patients with an aggressive type of
non-Hodgkin lymphoma called primary mediastinal large B-cell lymphoma.
Pembrolizumab is intended for adults and children who have primary mediastinal large B-cell lymphoma that is refractory, meaning it is not responding to standard treatments, or that has relapsed after two more other treatments.
Non-Hodgkin lymphoma is the eighth type of cancer that the FDA has
approved pembrolizumab for treating. Pembrolizumab is also the only anticancer therapeutic approved to treat all types of solid tumor, regardless of the organ they originated in, if they have either of two specific biomarkers.
Pembrolizumab Use Expanded to Non-Hodgkin Lymphoma
In 2018, nearly 75,000 new cases of non-Hodgkin lymphoma are expected to be diagnosed in the United States, according to
data from the National Cancer Institute’s Surveillance, Epidemiology, and End Results (SEER) Program. There are, however, many different types of this form of cancer. Different types of non-Hodgkin lymphoma grow and spread at different rates. Those that grow and spread rapidly are referred to as aggressive lymphomas. This FDA approval of pembrolizumab is for an aggressive type of non-Hodgkin lymphoma called primary mediastinal large B-cell lymphoma.
According to the FDA announcement, the approval was based on results from the phase II KEYNOTE-170 clinical trial. Among 53 patients with relapsed or refractory primary mediastinal large B-cell lymphoma, six had a complete response and 18 had a partial response, giving an overall response rate of 45 percent.